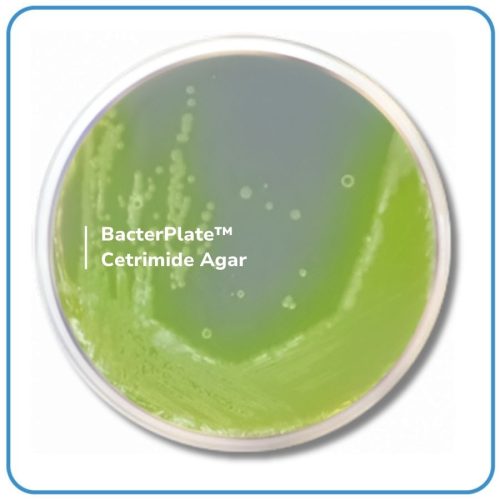

BacterPlate™ Cetrimide Agar
Mã: 05031
Mã đặt hàng/sản phẩm: 4102017
Số lượng tối thiểu: 1
Qui cách đóng gói:
10 đĩa/hộp
- BacterPlate™ Cetrimide Agar là môi trường chọn lọc dùng để phân lập và định lượng Pseudomonas aeruginosa từ các mẫu sinh học có nguồn gốc động vật và trong các sản phẩm dược phẩm và mỹ phẩm. Bao gói bằng màng bán thấm Cellophane film giúp cân bằng độ ẩm môi trường trong quá trình bảo quản.
- Thành phần trong 1L môi trường (tham khảo): Pancreatic digest of gelatin; Glycerol; Cetrimide; Magnesium chloride; Sulfate de potassium; Agar. pH của môi trường hoàn chỉnh ở 25°C: 7,3 ± 0,2.
- Quy cách: 10 đĩa/ hộp hoặc theo yêu cầu của khách hàng.
- Bảo quản lưu trữ: 2 – 8°C.
- Vận chuyển: Nhiệt độ môi trường.
- Hạn sử dụng: 04 tháng kể từ ngày sản xuất.
Danh sách đặt hàng
BacterPlate™ Cetrimide Agar
Mã: 4102017
Đơn vị: Đĩa
| Tên sản phẩm | Hình ảnh | Mã đặt hàng/sản phẩm | Đơn vị tính | Số lượng | Chọn vào giỏ hàng |
|---|---|---|---|---|---|
| BacterPlate™ Cetrimide Agar | ![]() | 4102017 | Đĩa |
